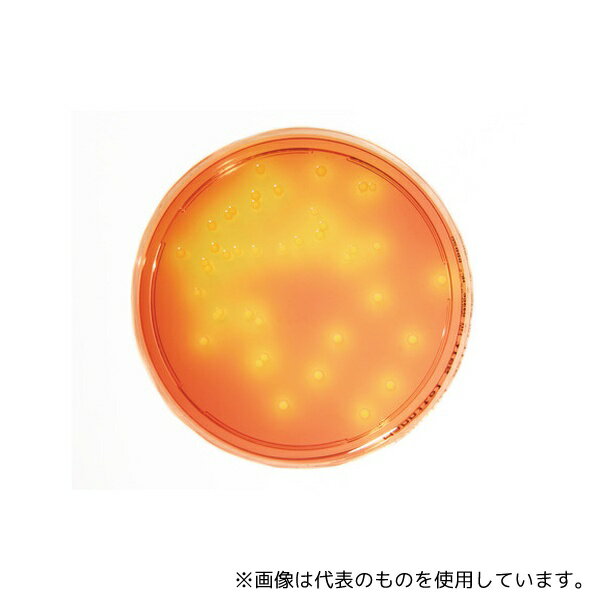
●Merck 1.46023.0020 特定微生物試験培地 マンニット食塩寒天培地 (30mL×20枚入)
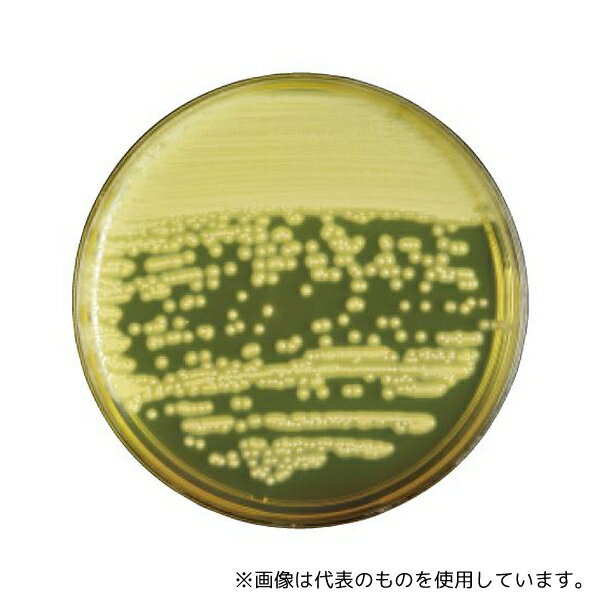
ベクトン・ディッキンソン 251977 BD BBL(TM) 卵黄加マンニット食塩寒天培地 20枚
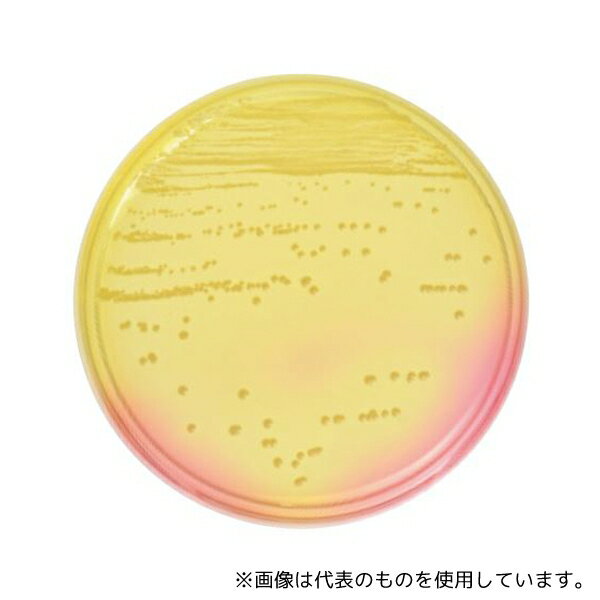
ベクトン・ディッキンソン 251173 BD BBL(TM) マンニット食塩寒天培地 20枚

コージンバイオ株式会社 食品工場で多数実績あり『卵黄加マンニット食塩寒天培地』

栄研 E―KE08|||マンニット食塩培地 分包顆粒/英贤E-KE08 | | |甘露醇盐琼脂袋颗粒栄研 E―KE08|||マンニット食塩培地 分包顆粒-36-0411

●Merck 1.46023.0020 特定微生物試験培地 マンニット食塩寒天培地 (30mL×20枚入)

Incident ID: 2443b682-bohn-42df-a556-7e678161893d IP Address : 219.104.25.38
●Merck 1.46023.0020 特定微生物試験培地 マンニット食塩寒天培地 (30mL×20枚入)

Incident ID: 0816b24e-bohn-4228-8462-d62632b30363 IP Address : 219.104.25.38

Incident ID: 076522dc-bohn-4a8b-8f51-60113472603d IP Address : 219.104.25.38

栄研化学 PK0004 ぺたんチェックII25 卵黄加マンニット食塩寒天培地 1箱(10枚×4袋入)

キーワード解説実業団連盟への新規チーム登録について2015年度硫黄島訪島事業 ガイダンス【紫外線注意報発令中です】そ の 他編レシピはこちらPDFファイルへのリンクですチラシ - 一般社団法人 日本理科教育学会自動小口染色システムの実用化試験2009年10月 - 日本サーバス小学校5年生「もののとけ方」教師用 - 国土交通省講演会「福島廃炉、環境回復に関する化学研究開発の最前線およびそのローヤルゼリー Royal Jelly - Nu Skin横浜ロイヤルパークホテル ご宿泊オプション血漿分画製剤(人血清アルブミン製剤)【11月5日】 新ディスポーザブル・プラスチックピペット追加販売のお知らせJA-10 -1 - ベックマン・コールターPDFダウンロードはこちら新ひだかソーラーパーク ニュースリリースのご案内 NEW!EMの増やし方 ①sCLARITYJLA-8.1000 - ベックマン・コールターexpydoc.comYour ExpyDoc

アスクルオリエンタル酵母工業 食品用寒天平板生培地 卵黄加マンニット 1箱(100枚) 6-9729-13(直送品)

未分類 暇をみてNO①寒天培地を作ってみました。 おすすめこのサイトについて

ベクトン・ディッキンソン 251977 BD BBL(TM) 卵黄加マンニット食塩寒天培地 20枚
ベクトン・ディッキンソン 251977 BD BBL(TM) 卵黄加マンニット食塩寒天培地 20枚

ベクトン・ディッキンソン BD BBL(TM) 卵黄加マンニット食塩寒天培地 20枚 251977 1個(1本×20枚入)

Incident ID: 650b71e3-bohn-45d6-93be-f3039f81deda IP Address : 219.104.25.38

2-6430-10 ぺたんチェック(R)10 SCD寒天培地 PT8010

未分類 暇をみてNO①寒天培地を作ってみました。 おすすめこのサイトについて

Merck 特定微生物試験培地 マンニット食塩寒天培地 (30mL×20枚入) 1箱(20枚入) 1.46023.0020

環境微生物学研究室 - 近畿大学生命科学科 環境微生物学研究室の紹介 EGU(欧州地球科学連合)2023年総会での口頭発表 牧教授おすすめ書籍その⑧ 『海洋化学研究』最新版に原稿掲載 黄砂サンプリング:牧レポート(京都) 黄砂サンプリング:牧レポート(大阪上空) 本日(4/13)の産経新聞にコメント掲載 能登での上空サンプリング

栄研化学 ぺたんチェック®DD MYP寒天培地 PD0017(20枚)

ベクトン・ディッキンソン BD BBL(TM) マンニット食塩寒天培地 20枚 251173 1個(1本×20枚入)

Incident ID: 48b4529d-bohn-4ba7-ad40-4000ab548cba IP Address : 219.104.25.38

Incident ID: 7790e167-bohn-43d6-a4d8-9dac518789c6 IP Address : 219.104.25.38

ベクトン・ディッキンソン 251173 BD BBL(TM) マンニット食塩寒天培地 20枚

Incident ID: 2498ab02-bohn-4c55-882a-da94c7a8a941 IP Address : 219.104.25.38

Incident ID: dd26f21a-bohn-4872-97d3-dd8dec3ded73 IP Address : 219.104.25.38

Incident ID: 129734af-bohn-487d-8417-4c4a81688e48 IP Address : 219.104.25.38

ベクトン・ディッキンソン BD BBL(TM) 卵黄加マンニット食塩寒天培地 100枚 1個(1本×100枚入) 251751

株式会社サンユー・埼玉県・飯能市・医療・試薬・消毒・日水製薬・栄研化学

Incident ID: b7b3a869-bohn-4e9c-a192-d005b4995178 IP Address : 219.104.25.38
ベクトン・ディッキンソン 251173 BD BBL(TM) マンニット食塩寒天培地 20枚

Incident ID: d3e4975a-bohn-469b-b084-abe5e971e535 IP Address : 219.104.25.38

Incident ID: 12544f9f-bohn-476d-b37f-4739c8face47 IP Address : 219.104.25.38